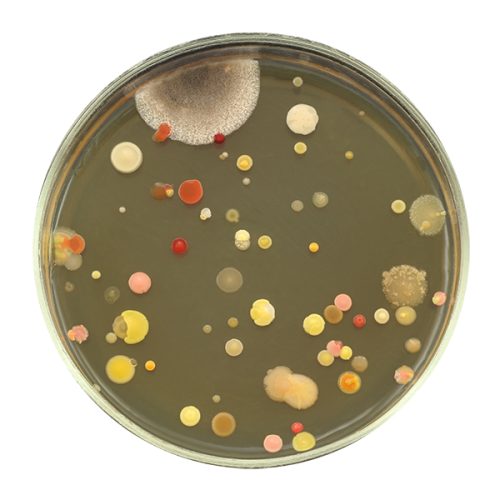

Los gerentes de laboratorio usualmente se encuentran con decisiones difíciles con respecto a la disponibilidad de los recursos, no sólo con respecto a la dotación de personal, sino también a la obtención de las herramientas más efectivas para el trabajo con una fuerte restricción presupuestaria.
Estas decisiones pueden tener un efecto significante en la eficiencia del procesamiento de muestras y los tiempos para reportar los resultados.
Introducción
Los gerentes de laboratorio usualmente se encuentran con decisiones difíciles con respecto a la disponibilidad de los recursos, no sólo con respecto a la dotación de personal, sino también a la obtención de las herramientas más efectivas para el trabajo con una fuerte restricción presupuestaria. Estas decisiones pueden tener un efecto significante en la eficiencia del procesamiento de muestras y los tiempos para reportar los resultados. Por su propia naturaleza, el trabajo de microbiología es generalmente muy intensivo, consume mucho tiempo y requiere destreza y experiencia. Mientras que los nuevos métodos rápidos de análisis de muestras, como PCR en tiempo real y otras técnicas moleculares automatizadas, inevitablemente generan un aire de excitación entre los científicos y representan importantes avances en la tecnología científica, la importancia y relevancia de los avances en los métodos de cultivo en la microbiología rutinaria no debe ser olvidada o ignorada. La introducción de nuevos medios de cultivo es un factor crucial que puede tener un significante impacto en la rentabilidad, precisión y rapidez de los resultados de los laboratorios de alimentos, agua, clínicos e industriales de todo el mundo.
Medios de cultivo
Por más de un siglo, desde el trabajo de Robert Koch con “la mezcla de nutrientes líquidos y gelatina”, los medios de cultivo sólidos han sido usados para el cultivo de formaciones de microorganismos en constante expansión. Fue el trabajo de Walther Hesse (1846-1911) y su esposa Fanny (née Eilshemius) (1846-1934) el que estableció el uso de agar como un agente gelificante superior para los medios sólidos1. El principal problema con tales medios nutritivos de uso general fue la incapacidad para distinguir entre organismos patógenos y no patógenos solo por características morfológicas. En un tiempo cuando se estaban descubriendo muchas nuevas cepas, la identificación microbiana y la taxonomía estaba en su infancia y la necesidad de establecer perfiles bioquímicos de las especies bacterianas (y así proporcionar un medio para la diferenciación) se hizo evidente. Sin embargo, esto necesitó de extensivas pruebas de colonias individuales de crecimiento bacteriano y fue un trabajo altamente intensivo. Además, el trabajo debía ser muy meticuloso y la experiencia estaba en las manos de unos pocos.
Gradualmente, mientras más se sabía acerca de las diferencias bioquímicas entre diferentes géneros y especies (por ejemplo la habilidad para degradar ciertas sustancias o producir sustancias bioquímicas específicas tales como puntos finales del metabolismo), los medios de cultivo fueron evolucionando para incorporar componentes adicionales, tales como fuentes de carbohidratos específicos y un indicador de pH adecuado, para ayudar la identificación diferencial. Los agentes inhibidores (por ejemplo sales biliares, ciertos colorantes y otros compuestos) también se convirtieron en un ingrediente usado comúnmente para reducir o eliminar el crecimiento de organismos no deseados. Así, los medios pudieron ser clasificados como selectivos tanto como diferenciales. Un ejemplo clásico de esto es el Agar MacConkey (imagen 1), que contiene lactosa y rojo neutro para la diferenciación de organismos fermentadores de lactosa, junto con sales biliares para la inhibición de especies sensibles a la bilis. Estas propiedades lo hacen útil en la identificación de patógenos intestinales como salmonellas (de importancia en microbiología clínica, de alimentos y agua), que son generalmente no fermentadoras de lactosa (NLF), así como comensales como Escherichia coli que pueden fermentar lactosa (un indicador clave de contaminación fecal, también importante en microbiología de alimentos, agua e industrial).

Imagen 1
En muchos casos, la especificidad de los medios selectivos convencionales fue mejorada por la adición de antibióticos suplementarios para inhibir organismos indeseados. Un ejemplo de estos es el Agar Manitol Salado con oxacilina para la detección y aislamiento de Staphylococcus aureus resistentes a la meticilina (MRSA) (Imagen 2). Muchas variantes de S. aureus son halófilas y capaces de fermentar el manitol. Solo aquellos resistentes a la oxacilina (el primer marcador sustituto ampliamente usado para resistencia a la meticilina) son capaces de sobrevivir a la presencia de este antibiótico. Dichos organismos aparecen como colonias amarillas con halos amarillos en este medio. Sin embargo, debido a otros Staphylococci clínicamente menos significantes (por ejemplo S. haemolyticus) que también poseen estas cualidades, se encuentra un número significantes de falsos positivos. Esto tiene un efecto significante en el aumento del volumen requerido de pruebas confirmatorias. También, hay variantes emergentes de MRSA que son incapaces de fermentar manitol resultando en falsos negativos.

Imagen 2
Aunque los medios selectivos diferenciales redujeron en el volumen y grado de las pruebas confirmatorias requeridas comparado con el Agar nutritivo original, su especificidad total se mantiene relativamente limitada. A pesar de sus limitaciones, muchos de estos tipos de medios siguen siendo herramientas microbiológicas útiles y son ampliamente utilizados hoy en día.
Dado el extendido uso de sustratos cromogénicos y fluorogénicos en bioquímica, es algo sorprendente que su aplicación a microbiología no tuvo éxito hasta la década del 80. El catalizador para la investigación en este campo fue el deseo de los microbiólogos del agua para desarrollar un método de detección rápida para el indicador fecal E. coli2. Desde el trabajo de Feng y Hartman3, quienes fueron pioneros en el uso de 4-metilumbeliferona-β y D-glucorinde para la detección de E. coli en muestras de agua y alimentos, se produjo una explosión en la investigación y desarrollo en el campo de los medios de cultivo cromogénicos.
Sustratos cromogénicos
Un sustrato cromogénico puede ser definido como “un compuesto o sustancia que contiene un grupo formador de color”4. Los sustratos cromogénicos comercialmente sintetizados (o cromógenos) están disponibles para la detección de muchas enzimas hidrolasas, incluyendo glicosidasas, peptidasas, fosfatasas y esterasas (Tabla 1). Este grupo de enzimas incluye varios productos génicos específicos para cierto género (o en algunos casos especie) de bacterias y su detección a menudo puede ser una ayuda invaluable para la diferenciación e identificación. Esto puede reducir significativamente la cantidad de trabajo requerido para confirmar la identidad y el significado de la colonia sospechada.
Las glicosidasas exhiben especificidad no solo por el tipo de azúcar, sino por su conformación estérica (D- o L-) y la conformación del enlace glucosídico (α- o β-)2. Por ejemplo los cromógenos β-D-glucósidos son específicos para detectar actividad de β-D-glucosidasa y su utilidad en la diferenciación bacteriana está bien documentada5-7.

Tabla 1
Cromóforos indoxilo
La detección de actividad de hidrolasa específica puede ser lograda por la adhesión de un cromóforo (el “grupo formador de color”) al sustrato objetivo, de manera que la hidrólisis del sustrato produce un color específico, dependiendo del tipo de cromóforo usado. Varios tipos están disponibles, pero el más comúnmente usado en medios de cultivo sólidos son los derivados del indoxyl. En su forma más simple, el indoxyl un compuesto incoloro, soluble en agua que se oxida rápidamente en el aire para formar azul índigo, un compuesto dimérico coloreado insoluble. (Imagen 3).

Imagen 3
En la práctica, el indoxyl generalmente muestra un color débil cuando se usa en medios de cultivo, pero el anillo indoxyl puede ser modificado por la adición de uno o más halógenos en ciertas partes del mismo. Esto produce cambios en la absorbancia en el espectro visible y consecuentemente muestra un producto final de diferente color. En la imagen 4 se muestran ejemplos de cromóferos basados en indoxyl comúnmente usados y sus respectivos colores. Además, se pueden lograr cambios sutiles en sus colores e intensidad por la inclusión de otros componentes en el medio (por ejemplo: cationes, peptonas, inductores, etc.).

Imagen 4
Medios de cultivo cromogénicos
La incorporación de más de un cromógeno en un medio puede mejorar sus propiedades de especificidad y diferenciales. Un medio que contiene 5-bromo-4-cloro-3-indoxil β-D-glucopiranosida (X-Gluc) y 6-cloro-3-indoxil β-D-galactopiranosida (red-Gal) es útil para la diferenciación de potenciales patógenos del tracto urinario, como muestran las imágenes 5 y 6.

Imagen 5

Imagen 6
Los organismos que expresan β-galactosidasa escinden el sustrato red-Gal para producir colonias rosas/rojas (por ejemplo E. coli), mientras que la expresión de β-glucosidasa resulta en una escisión del X-Gluc para formar colonias verdes (por ejemplo Enterococcus spp.). La expresión de ambas enzimas resulta en colonias de un azul-violeta oscuro y es indicativo de Klebisiella, Enterobacter o Serratia spp. (grupo KES). Staphylococci (con la principal excepción de S. saprophyticus) y streptococci no producen ninguna de esas enzimas y crecen como colonias blancas o incoloras. La diferenciación de estos géneros se establece rápidamente por una prueba de catalasa (los estafilococos son positivos para esta enzima, y los estreptococos negativos). Proteus spp. puede ser diferenciado por la inclusión of triptófano, formando colonias color canela debido a la reacción del triptófano con la deaminasa (TDA).
Esta tecnología también se aplicó a la diferenciación de Candida spp. con el uso de cromógenos de indoxil para detectar la presencia de hexosaminidasa y fosfatasa alcalina. Esto está ilustrado en la imagen 7.

Imagen 7
La solubilidad de los sustratos iniciales y la insolubilidad de los productos finales son características que hacen al grupo indoxil de cromóferos particularmente útiles para su uso en medios de cultivo sólidos. Esto es debido a que la coloración está restringida a la masa celular, permitiendo a las colonias de especies que poseen la hidrolasa pertinente, ser fácilmente reconocibles en un cultivo mixto. Un inconveniente de los cromógenos de indoxyl es su dependencia de la oxidación, haciéndolos inútiles para la detección de bacterias anaeróbicas. Se han descrito cromógenos alternativos para superar este problema, en particular, los quelantes de metales (por ejemplo esculina, 8-hidroxiquinolina, dihidroxiflavonas y alizarina).2,8
Otros cromóforos
Otros cromóforos, tales como nitrofenol y nitroanilina, están disponibles en una variedad de formas de sustrato. En efecto, el orto-nitrofenol-β-D-galactosida (ONPG) es aún ampliamente usado en la diferenciación bioquímica de bacterias. Sin embargo, los sustratos de nitrofenol y nitroanilina sufren dos contratiempos: tienen un coeficiente de extinción bajo, generalmente resultando en poca sensibilidad dado a una insuficiente producción de color; y su producto final es altamente soluble, haciéndolos más útiles para ensayos líquidos (caldo) que para medios sólidos. Los sustratos de nitroanilina (y otros contenedores de amina) son particularmente útiles para la detección de amino-peptidasas cuando se junten con un péptido. Sin embargo, esto requiere la adición de un revelador (usualmente dimetilaminocinamaldehido) para manipular la reacción de color observada (formación de la base Schiff) y esto los hace poco prácticos para su uso en medios de cultivo sólidos.
Beneficios de los medios cromogénicos
Un amplio rango de medios cromogénicos están disponibles comercialmente para la detección de muchos organismos de significación en microbiología de agua, alimentos, clínica e industrial (por ejemplo Listeria, Salmonella, Bacillus cereus, clostridios, Candida, enterococos, estafilococos, E. coli y coliformes). Los principales beneficios de estos medios sobre los convencionales son su sensibilidad y especificidad mejoradas. En algunos casos la sensibilidad mejorada puede conducir a una reducción del tiempo de incubación (por ejemplo agars cromogénicos para detección de MRSA), permitiendo un tiempo más rápido del reporte de resultados. Estas propiedades también los hace ideales como medios de cribado de alto volumen debido a la reducción resultante en las pruebas confirmatorias requeridas. Desde la perspectiva de un encargado de laboratorio, los beneficios clave de los medios cromogénicos pueden ser resumidos de la siguiente manera:
Facilidad de uso e interpretación:
Entrenamiento requerido mínimo.
Permite un uso más apropiado del personal experimentado.
Rendimiento mejorado:
Mas confianza en los resultados comparado con los medios convencionales.
Resultados más rápidos.
Volumen reducido del trabajo de seguimiento.
Rentabilidad:
Pruebas confirmatorias reducidas, evitan costo extra de medios.
Significativamente más barato que un PCR u otros métodos moleculares automáticos.
Aunque las técnicas moleculares están ganando reconocimiento y credibilidad rápidamente para ciertas aplicaciones, debido a que son caras, generalmente son rentables para una gran cantidad de muestras o cuando la detección no es posible por maneras convencionales. Estas técnicas no permiten cultivos subsecuentes del organismo. Esto no es un problema necesariamente en ciertas circunstancias, pero puede ser una desventaja importante, especialmente en algunos escenarios, donde se requiere una caracterización fenotípica posterior (por ejemplo patrones de sensibilidad antimicrobiana). La mayor ventaja de los sistemas moleculares es un menor tiempo en los resultados. El impacto de esto en términos reales puede ser medido solo por la eficiencia en el sistema de reporte por sí mismo y en algunos casos puede no haber ningún beneficio con respecto al tiempo.
Sobre todo, los medios cromogénicos representan una manera rentable de conseguir una sensibilidad y especificidad mejorada de resultados sin el costo de técnicas moleculares automatizadas. Otras aplicaciones de tecnología cromogénica se están encontrando todo el tiempo y están limitadas solo por la búsqueda de mas sustratos diferencialmente útiles.
Referencias
Bridson, E.Y. The development, manufacture and control of Microbiological culture media. Unipath Ltd. 1994.
Bovill, R., Druggan, P. The use of chromogenic enzyme substrates in microbial identification. Culture 2005; 26(2): 5-8.
Feng, P.C., Hartman, P.A. Fluorgenic assays for immediate confirmation of Escherichia coli. 1982; Appl. Environ. Microbiol. 43: 1320-1329.
Azaid, A., Hughes, H.H., Porceddu, E., Nicholas, F. Glossary of biotechnology and genetic engineering. 1999. Series title: FAO Research and Technology Papers – 7.ISBN: 9251043698. Available from: http://www.fao.org/docrep/003/X3910E/X3910E00.HTM, cited 27th April 2007.
Bascomb, S. Enzyme tests in bacterial identification. Methods Microbiol. 1987; 19: 105-160.
Kaufhold, A., Lϋtticken, R., Schwien, U.Few-minutes test for the identification of group A streptococci and enterococci with chromogenic substrates. 1989. Zentralbl. Bakteriol. 272: 191-195.
Manafi, M., Kneifel, W., Bascomb, S. Fluorogenic and chromogenic substrates used in bacterial diagnostics. Microbiol. Reviews 1991; Sept: 335-348.
Perry, J., Morris, K., James, A., Oliver, M., Gould, F. Evaluation of novel chromogenic substrates for the detection of bacterial b-glucosidase. Journal Appl. Microbiol. 2007; 102: 410-415.—